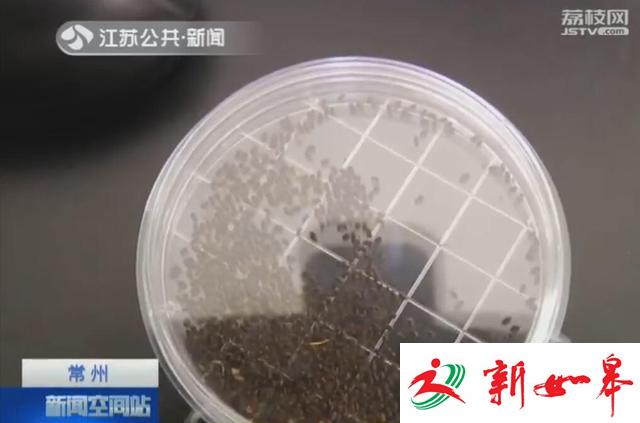
e520002b58a7a288f4a

长假出国游玩,很多人都会带点当地特产回来,近日,一位游客从老挝捎带野生灵芝回国,在常州机场入境时,灵芝中被查出活体的"长蠹木蕈甲",这在全国口岸也是首次发现。
塑料盒内密密麻麻,长约2毫米的黑色小虫,就是经过培养成熟的长蠹木蕈甲,当时它们就躲在这些野生灵芝里。常州出入境检验检疫局在X光机过机行李查验中,发现一位中国籍旅客,携带了野生灵芝,随后现场检疫查验发现,灵芝上带有虫孔。
经过实验室培养,虫孔里带有活虫长蠹木蕈甲,这是一种影响植物生长的害虫,这批携带活虫的灵芝,已被工作人员采取高温高压灭菌措施进行销毁。目前,国内的野生灵芝每斤售价超过300元。相比之下,老挝的野生灵芝较为便宜,因此一些市民回国时,经常会捎带这些中药材。但是野生的中药材,生长环境恶劣,容易出现虫咬虫蛀,在购买时不容易被发现。
此外,来自东南亚的辣木籽,民间认为具有降低血压和血糖的功效,也受到不少消费者的追捧。但是医生介绍,在我国药典上,并没有这个品种,辣木籽既不能算作药材,也不是保健品。







最新评论